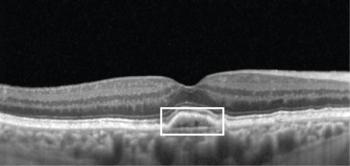

From Stargardt to macular telangiectasia type 2, Kensington Hatcher, OD, FAAO, FORS; and Srinivas Kondapalli, MD, detail other conditions that share similarities to AMD.

From Stargardt to macular telangiectasia type 2, Kensington Hatcher, OD, FAAO, FORS; and Srinivas Kondapalli, MD, detail other conditions that share similarities to AMD.

At Vision Expo East 2024, Srinivas Kondapalli, MD, demonstrates how to use Rinsada to address ocular surface disease.

An overview of current ocular biofilm removal procedures
Imaging can elucidate visual prognosis and disease progression risk.

Published: March 27th 2023 | Updated: